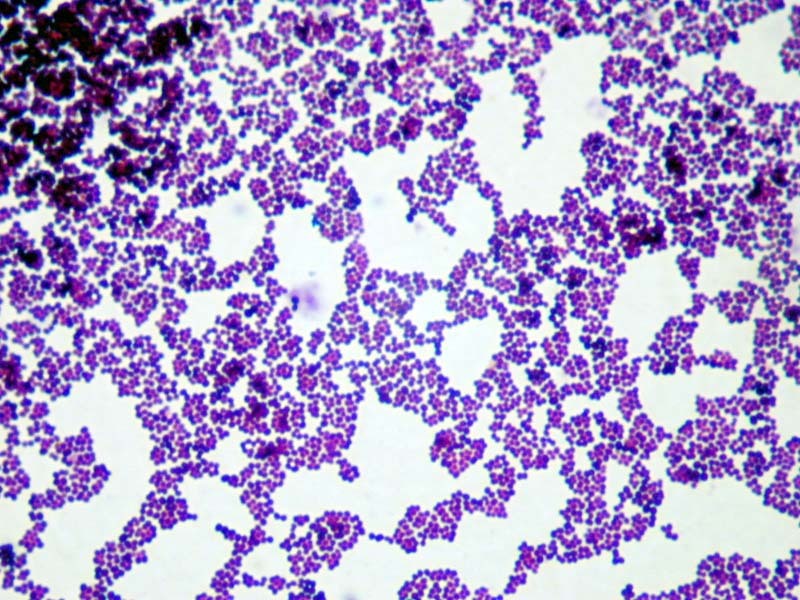
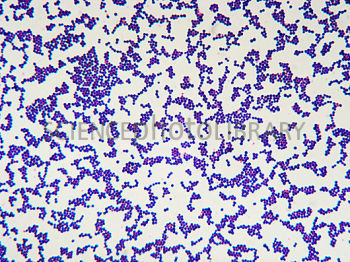

1
Q

A
Alcaligenes faecalis
Gram negative
Diplococcus
Slight yellow
Non-Motile
Catalase Positive
Small Colonies
2
Q

A
Proteus mirabalis
Gram negative
Single Rod
Brownish Colony
Motile
Catalase Positive
Brown Agar
3
Q
A
Staplycoccus epidermidis
Gram positive
Coccus clusters
Off whitish
Non-motile
Catalase Positive
Small colonies
4
Q

A
Proteus vulgaris
Gram negative
Single Rod
Brownish colony
Non motile
Catalase Positive
Brown agar
5
Q

A
Bacillus cereus
Gram positive
Single/ chains Rods
Off white colonies
Slightly motile
Catalase positive
Large crusty colonies
6
Q
A
Staphylococcus aureus
Gram positive
Clusters of coccus
Cream/ golden colonies
Non motile
Catalase positive
Medium colonies


